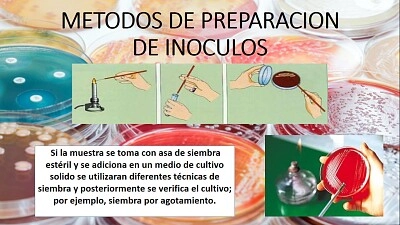

|
||||||||
|
|
||||||||
|
Twój czas 00:00
|
||||||||
|
Średni czas
00:21
|
||||||||
|
Najlepszy czas
01:31
|
||||||||
 |
||||||||
|
|
||||||||
|
||||||||||||||||||||||||||||
BIOTECNOLOGIATe puzzle należą do albumu użytkownika My Album Właściciel albumu: Stephania38
Najlepszy wynik: ELetito Osiągnięty dnia2021-07-08 Autor zdjęcia i prawa autorskie:QUIMICA |
||||||
| BIOTECNOLOGIA - 25 Elementów | |||||
| Twój czas: |
|
||||
| Pokaż większe elementy puzzli za małymi? Tak Nie | |
| Udostępnij te puzzle |
|
| |